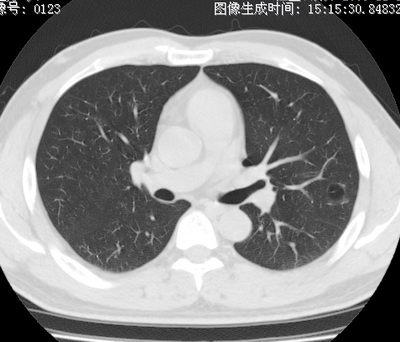
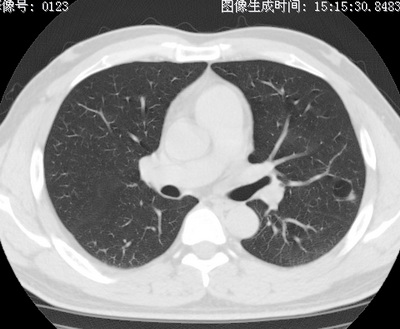
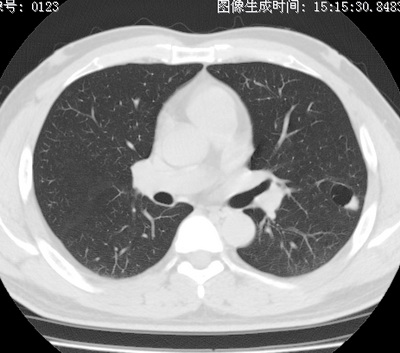
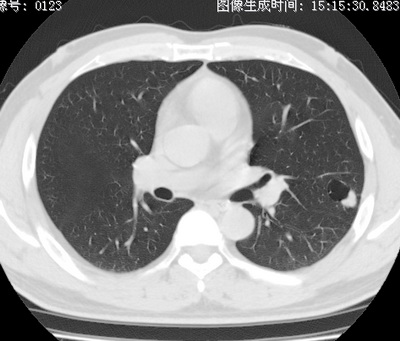
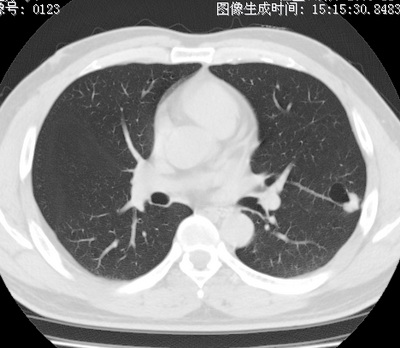

以下是引用zhao_bin2008在2010-1-4 20:15:00的发言:[br]先天性肺囊肿或小的肺隔离症?
以下是引用卜一在2010-1-4 22:09:00的发言:[br]先天性肺囊肿或小的肺隔离症?支持!
以下是引用zsl6918在2010-1-5 5:23:00的发言:[br]良性改变!肺囊肿,先天性支气管闭锁,血管畸形等均有可能。
以下是引用影像之路在2010-1-6 11:10:00的发言:[br]腺癌,最终的病检有些出乎意料之外,术前同志们大多考虑为肺囊肿或小的肺隔离征 [br]回过头来看 小结节呈分叶状,其内侧有一条较粗的静脉供血或许能成为支持诊断腺癌的理由
| 欢迎光临 医影在线 (http://bbs.radida.com/bbs/) | Powered by Discuz! X3.2 |